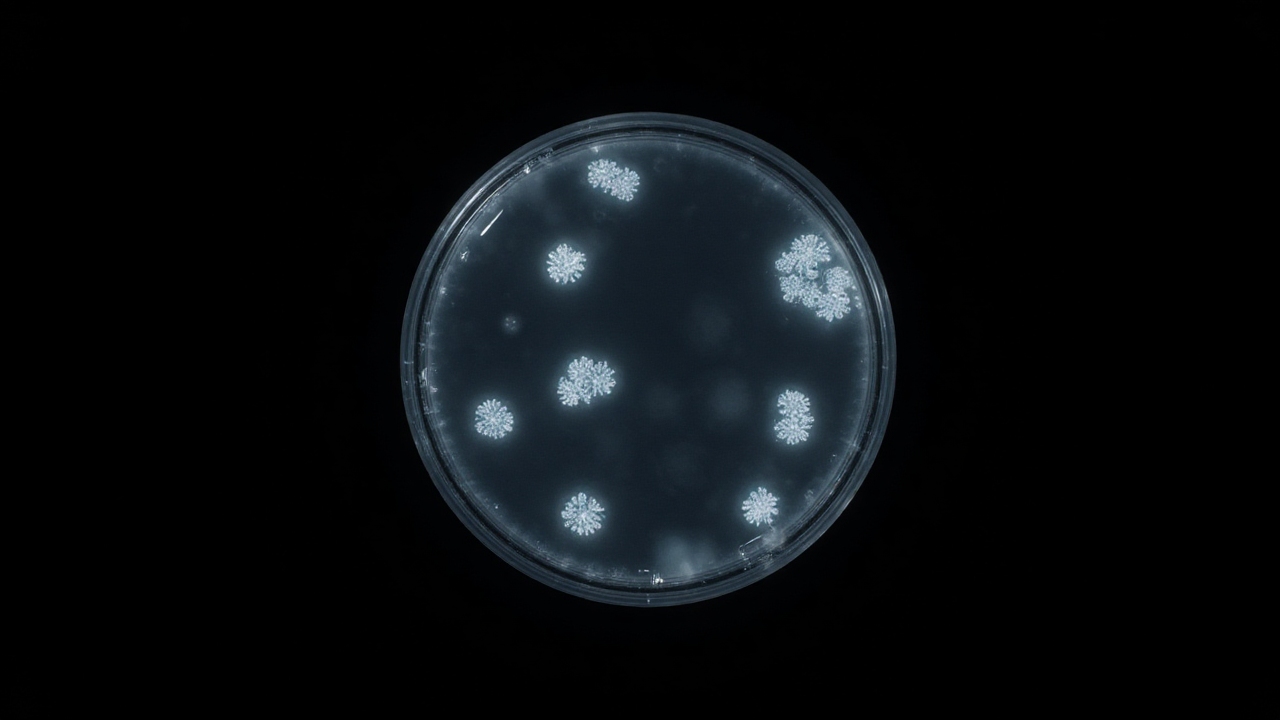
Synergia ciprofloksacyny i berberyny w zwalczaniu P. aeruginosa

Wprowadzenie do problematyki ciprofloksacyny w rolnictwie
Ciprofloksacyna (CIP), powszechnie stosowany antybiotyk z grupy fluorochinolonów, staje się coraz większym problemem środowiskowym, zwłaszcza w kontekście rolnictwa. Wraz z intensyfikacją stosowania antybiotyków w medycynie ludzkiej oraz hodowli zwierząt, ich obecność w glebie rośnie, co może prowadzić do poważnych konsekwencji dla produkcji rolniczej i bezpieczeństwa żywności. Badania wykazały, że ciprofloksacyna może negatywnie wpływać na wzrost roślin, co budzi obawy dotyczące jakości upraw i ich bezpieczeństwa dla konsumentów. W odpowiedzi na te wyzwania, nowe badania naukowe dostarczają istotnych informacji na temat skuteczności zastosowania nanoproszków biocharu (BNPs) jako strategii ochrony roślin przed stresem wywołanym przez antybiotyki.
Badania nad zastosowaniem biocharu w walce z ciprofloksacyną
W badaniach przeprowadzonych na siewkach ryżu stwierdzono, że BNPs skutecznie redukują negatywne skutki działania ciprofloksacyny. W eksperymentach zastosowano stężenia ciprofloksacyny wynoszące 5 i 10 mg L−1, w połączeniu z BNPs w ilości 0.2 g L−1. Wyniki pokazały, że ciprofloksacyna znacząco zakłócała wzrost roślin, prowadząc do zmniejszenia długości pędów o 20,5% oraz długości korzeni o 45,2%, a także obniżenia biomasy. Wprowadzenie BNPs skutecznie zmniejszyło biodostępność ciprofloksacyny o ponad 80%, co zaowocowało zmniejszeniem akumulacji ciprofloksacyny o 49,7% w pędach oraz 33,1% w korzeniach. Co więcej, BNPs przyczyniły się do poprawy wzrostu roślin, przywracając długość pędów do 98,2% wartości kontrolnych przy stężeniu 5 mg L−1 ciprofloksacyny oraz poprawiając wzrost korzeni i akumulację biomasy.
Wyniki badań: szczegółowa analiza wpływu BNPs na siewki ryżu
Właściwości fizykochemiczne biocharu nanoproszkowego
Analiza właściwości BNPs wykazała, że ich średnica wynosiła 50 ± 5 nm, co znacząco zwiększa ich zdolności adsorpcyjne. Badania wykazały, że BNPs efektywnie adsorbują ciprofloksacynę poprzez różne mechanizmy, takie jak interakcje elektrostatyczne oraz wiązania wodorowe. Ponadto, różnorodność funkcji powierzchniowych BNPs, takich jak grupy hydroksylowe i aromatyczne, przyczynia się do ich zdolności do interakcji z cząsteczkami ciprofloksacyny.
Wpływ ciprofloksacyny na rozwój roślin i równowagę hormonalną
Ekspozycja na ciprofloksacynę wywołała znaczące zmiany w poziomach hormonów roślinnych w siewkach ryżu. Stwierdzono, że ciprofloksacyna zmniejsza poziom indol-3-octowego kwasu (IAA) o 14,5% przy stężeniu 5 mg L−1, podczas gdy przy stężeniu 10 mg L−1 poziom IAA wzrastał o 15,8%. Ponadto, BNPs przyczyniły się do odbudowy równowagi hormonalnej, zwiększając poziomy IAA o 8,9% oraz 6-benzylaminopuryny (6-BA) o 152,6% w przypadku 5 mg L−1 ciprofloksacyny.
Odzyskiwanie wzrostu roślin po zastosowaniu BNPs
Wprowadzenie BNPs do gleby spowodowało znaczące poprawy w parametrach wzrostu roślin. Długość pędów siewek, które były narażone na ciprofloksacynę i jednocześnie otrzymywały BNPs, przywróciła się do wartości zbliżonych do grupy kontrolnej. W przypadku 5 mg L−1 ciprofloksacyny długość pędów wzrosła do 28,33 cm, co jest statystycznie porównywalne z grupą kontrolną. Zmiany te wskazują na pozytywny wpływ BNPs na wzrost roślin nawet w warunkach stresu antybiotykowego.
Dyskusja nad wynikami badań i ich implikacjami
Znaczenie hormonów w regulacji wzrostu roślin
Wyniki badań sugerują, że ciprofloksacyna wywołuje złożone zmiany w równowadze hormonalnej siewek ryżu, co wpływa na ich rozwój. Obserwowane zmiany w poziomach hormonów, takie jak IAA i 6-BA, wskazują na skomplikowaną interakcję między ciprofloksacyną a metabolizmem hormonów roślinnych. Zmiany te mogą prowadzić do zaburzeń w procesach wzrostu, co potwierdzają wyniki dotyczące długości pędów i korzeni.
Mechanizmy adsorpcji i usuwania ciprofloksacyny
BNPs wykazały niezwykłą skuteczność w redukcji stresu spowodowanego ciprofloksacyną. Mechanizmy adsorpcji, oparte na unikalnych właściwościach fizykochemicznych BNPs, umożliwiły znaczną redukcję biodostępności ciprofloksacyny, co przyczyniło się do poprawy wzrostu roślin. Badania potwierdzają, że mniejsze cząstki biocharu wykazują wyższe zdolności adsorpcyjne dla antybiotyków, co jest zgodne z obserwacjami innych badaczy.
Podsumowanie i wnioski
Badania wykazały, że BNPs skutecznie łagodzą stres wywołany ciprofloksacyną w siewkach ryżu poprzez różne mechanizmy, w tym bezpośrednie zmniejszenie biodostępności ciprofloksacyny oraz przywrócenie równowagi hormonalnej. Stwierdzono, że BNPs przyczyniają się do poprawy wzrostu roślin, co może stanowić obiecującą strategię w zarządzaniu zanieczyszczeniami antybiotykowymi w systemach rolniczych. Przyszłe badania powinny skupić się na optymalizacji zastosowania BNPs w różnych warunkach glebowych i dla różnych gatunków roślin.
Bibliografia
Chen Xiaohan, Chen Jieyu, Zhang Yanhong, Ling Chen and Shen Yu. Biochar Nanoparticles Reduce Ciprofloxacin Accumulation and Restore Growth and Hormonal Balance in Rice Seedlings. Plants 2025, 14(3), 5955-5963. DOI: https://doi.org/10.3390/plants14030380.